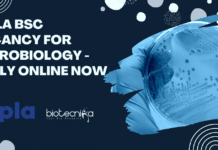
Cipla BSc Vacancy For Microbiology

Home 2024
Yearly Archives: 2024
Apply at Dr. Reddy’s Institute of Life Sciences For Junior Research Fellow Post
DRILS Molecular Biology JRF Job - Cell Biology Vacancy Available
Application for Junior Research Fellows in DBT funded project for 3 years
Applications are invited for...
IPCA Labs Hiring Microbiology Candidates For Executive Role – Apply Now
IPCA Labs Hiring Microbiology Candidates For Executive Role - Apply Now
Executive / Officer / Microbiologist ( Sterile Plant Exp. required )For Dehradun Dehradun, Uttarakhand,...
Associate or Senior Editor Position at Nature Communications (Cancer Genomics)! Apply Now!
Springer Nature Editor Job Openings for PhD Computational Biology
Associate or Senior Editor, Nature Communications (Cancer genomics)
Date: May 22, 2024
Location: Shanghai, CN Madrid, ES New...
FREE Download Cheat Sheet PDF For CSIR NET Life Science UNIT 4
The CSIR NET Life Science exam is just a few days away. Now is the time to gear up your preparation, especially revisions, with...
Cipla BSc Vacancy For Microbiology – Apply Online Now
Cipla BSc Vacancy For Microbiology - Apply Online Now
Junior Team Member - Microbiology
Posting Date: 21 May 2024
Country: India
State: Goa
Location: Rangpo
Req Id: 83327
Job Purpose
Execute analysis...
Research Technician at Beckman Coulter Life Sciences – Apply Now!
Research Technician at Beckman Coulter Life Sciences - Apply Now!
Research Technician – R&D
Beckman Coulter Life Sciences
Bangalore, Karnataka, India
Category: Other
Job Id: R1267088...
CSIR-NET June 2024 Exam Extension of Registration – Apply Now & Beat The Deadline!
CSIR-NET June 2024 Last Date Extension - Check New Dates!
PUBLIC NOTICE
21.05.2024
EXTENSION OF LAST DATE FOR SUBMISSION OF ONLINE APPLICATIONS FOR JOINT CSIR-UGC NET EXAMINATION...
IISc-Centre for Brain Research Life Sciences Job Opportunity – Apply Now!
IISc-CBR Life Sciences Research Jobs - Apply Now
Job Opportunity for Research Assistant in Dr. Jonas Lab (Clinical)
Qualification (Essential)
MBBS / MPH / Master’s degree...
Biotecnika Times Newsletter 21.05.2024 – Rs. 2.4 Lakh pm Pay Jobs at BIRAC, Govt...
Get Paid Up to Rs. 2.4 Lakh pm For Biotech, Biochem, Microbiology, Biological & Life Sciences at BIRAC - Apply Online
Apply online for various...
Govt HRD Non-Medical Fellowships 2025-26 – Applications Invited
Govt HRD Non-Medical Fellowships 2025-26 - Applications Invited
Govt HRD Non-Medical Fellowships 2025-26. Interested and eligible applicants can check out all of the details on...
PGIMER Genetics, Genomics, Bioinformatics SRF Job Opening – Apply Now
PGIMER Genetics, Genomics, Bioinformatics SRF Job Opening - Apply Now
DEPARTMENT OF TRANSLATIONAL AND REGENERATIVE MEDICINE POSTGRADUATE INSTITUTE OF MEDICAL EDUCATION & RESEARCH, CHANDIGARH- 160...
Get Paid Up to Rs. 2.4 Lakh pm For Biotech, Biochem, Microbiology, Biological &...
BIRAC Jobs Microbiology - Biological, Life Sciences Apply Online
BIRAC Jobs Microbiology - Biological, Life Sciences Apply Online. BIRAC Jobs Microbiology - Biological, Life Sciences...
CSIR-CFTRI Project Vacancy For Life Sciences, Biotech, Biochem – Apply Online
CSIR-CFTRI Project Vacancy Food Sciences, Life Sciences, Biotech, Biochem - Apply Online
ADVERTISEMENT NO. PAT. 214/2024
Engagement to the position of Project Associate Level-II
CSIR – Central...
Exciting Project Associate Opportunity at CSIR-CFTRI! Food Science & Tech Apply Now!
CFTRI Food Science Job Opening - Apply Now For Project Post
ADVERTISEMENT NO. PAT. 213/2024
Engagement to the position of Project Associate Level-I
CSIR – Central Food...
Novonesis Formulation Executive Jobs For Biotech & Food Technology, Apply Online
Novonesis Formulation Executive Jobs For Biotech & Food Technology, Apply Online
JR. Executive Formulation
locations: Tal-Khalapur, Mumbai
time type: Full time
posted on: Posted Today
job requisition id: JR101655
Are...